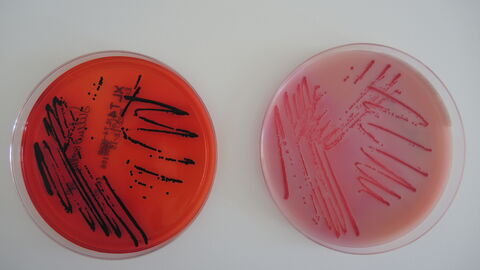
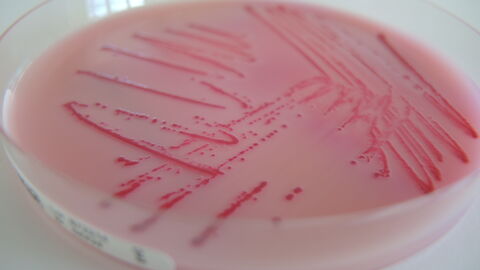

Nachweis von Salmonellen
Anzucht auf Agar-Platten
Bild (16:9) 1 Von 3
Salmonellen werden im Labor auf sogenannten Agar-Platten angezüchtet. Dabei bilden sie auf dem gelartigen Nährmedium optisch sichtbare Kolonien, wobei jede Kolonie aus unzähligen Salmonellen besteht (schwarze bzw. dunkelrote Objekte auf der Oberfläche)
Salmonellen werden im Labor auf sogenannten Agar-Platten angezüchtet. Dabei bilden sie auf dem gelartigen Nährmedium optisch sichtbare Kolonien, wobei jede Kolonie aus unzähligen Salmonellen besteht (schwarze bzw. dunkelrote Objekte auf der Oberfläche)
Bild (16:9) 2 Von 3

Bestimmte Selektivnährböden begünstigen das Wachstum bestimmter Bakterien: hier wachsen Salmonellen (schwarze Punkte und Linien) auf dem Selektivnährboden XLT4 (rote Substanz).
Bestimmte Selektivnährböden begünstigen das Wachstum bestimmter Bakterien: hier wachsen Salmonellen (schwarze Punkte und Linien) auf dem Selektivnährboden XLT4 (rote Substanz).
Bild (16:9) 3 Von 3
Bestimmte Selektivnährböden begünstigen das Wachstum bestimmter Bakterien: hier wachsen Salmonellen (rote Punkte und Linien) auf einem Selektivnährboden (Rambach-Agar, rosa Substanz).
Bestimmte Selektivnährböden begünstigen das Wachstum bestimmter Bakterien: hier wachsen Salmonellen (rote Punkte und Linien) auf einem Selektivnährboden (Rambach-Agar, rosa Substanz).